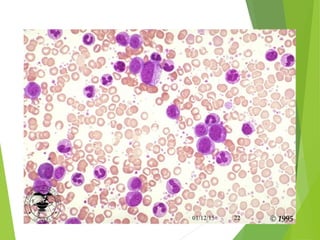
01/12/15 22

The document discusses chronic myelogenous leukemia (CML), detailing its epidemiology, clinical phases, and molecular pathogenesis, including the crucial BCR-ABL fusion gene. It emphasizes the role of various signaling pathways activated by BCR-ABL, treatment options like Imatinib, and mechanisms of resistance observed in patients. Additionally, it outlines laboratory features and diagnostic criteria for CML.